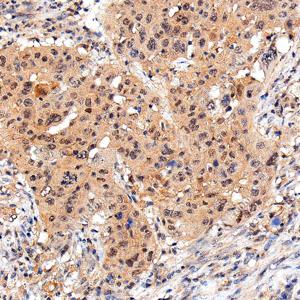
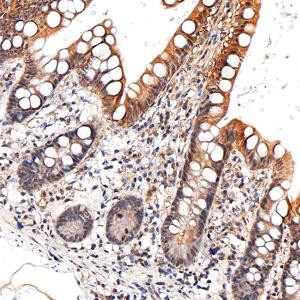
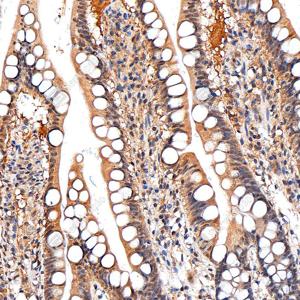

Recombinant Anti-STAT3 antibody (Mouse mAb)
- 100 μL
产品信息
蛋白质全称 | 信号转导与转录激活因子3 |
别名 | ADMIO, APRF, HIES, ADMIO1, Acute-phase response factor, STAT3 |
Uniprot ID | P40763 |
免疫原 | 人STAT3重组蛋白 |
抗体亚型 | IgG2a, κ |
克隆号 | SB693 2B4D1 |
纯化方式 | 亲和纯化 |
亚细胞定位 | 细胞核, 细胞质 |
应用
| 应用 | 物种 | 稀释 | 阳性样品 |
| IHC/IF 免疫组织化学/免疫荧光 | 人 | 1: 500-1: 1000 | 乳腺癌,食管癌 |
背景
Signal transducer and transcription activator that mediates cellular responses to interleukins, KITLG/SCF, LEP and other growth factors. Once activated, recruits coactivators, such as NCOA1 or MED1, to the promoter region of the target gene. May mediate cellular responses to activated FGFR1, FGFR2, FGFR3 and FGFR4. Binds to the interleukin-6 (IL-6)-responsive elements identified in the promoters of various acute-phase protein genes.
图像
| IHC检测STAT3蛋白(货号 GB15176). 样品: 人乳腺癌, 4%多聚甲醛 (货号G1101) 固定12-24小时. 抗原修复: 抗原修复仪(货号 ARI-4),Tris-EDTA抗原修复液(pH 9.0) (货号G1203), 水浴100℃, 25分钟. —抗: 1: 500稀释, 4℃ 孵育过夜. 二抗: S-vision免疫组化多聚二抗(山羊抗小鼠), 即用型(货号G1301), 室温孵育20分钟. |
| IHC检测STAT3蛋白(货号 GB15176). 样品: 人乳腺癌, 4%多聚甲醛 (货号G1101) 固定12-24小时. 抗原修复: 抗原修复仪(货号 ARI-4),Tris-EDTA抗原修复液(pH 9.0) (货号G1203), 水浴100℃, 25分钟. —抗: 1: 500稀释, 4℃ 孵育过夜. 二抗: S-vision免疫组化多聚二抗(山羊抗小鼠), 即用型(货号G1301), 室温孵育20分钟. |
| IHC检测STAT3蛋白(货号 GB15176). 样品: 人结肠, 4%多聚甲醛 (货号G1101) 固定12-24小时. 抗原修复: 抗原修复仪(货号 ARI-4),Tris-EDTA抗原修复液(pH 9.0) (货号G1203), 水浴100℃, 25分钟. —抗: 1: 500稀释, 4℃ 孵育过夜. 二抗: S-vision免疫组化多聚二抗(山羊抗小鼠), 即用型(货号G1301), 室温孵育20分钟. |
| IHC检测STAT3蛋白(货号 GB15176). 样品: 人结肠, 4%多聚甲醛 (货号G1101) 固定12-24小时. 抗原修复: 抗原修复仪(货号 ARI-4),Tris-EDTA抗原修复液(pH 9.0) (货号G1203), 水浴100℃, 25分钟. —抗: 1: 500稀释, 4℃ 孵育过夜. 二抗: S-vision免疫组化多聚二抗(山羊抗小鼠), 即用型(货号G1301), 室温孵育20分钟. |
| IHC检测STAT3蛋白(货号 GB15176). 样品: 人食管癌, 4%多聚甲醛 (货号G1101) 固定12-24小时. 抗原修复: 抗原修复仪(货号 ARI-4),Tris-EDTA抗原修复液(pH 9.0) (货号G1203), 水浴100℃, 25分钟. —抗: 1: 500稀释, 4℃ 孵育过夜. 二抗: S-vision免疫组化多聚二抗(山羊抗小鼠), 即用型(货号G1301), 室温孵育20分钟. |
| IHC检测STAT3蛋白(货号 GB15176). 样品: 人食管癌, 4%多聚甲醛 (货号G1101) 固定12-24小时. 抗原修复: 抗原修复仪(货号 ARI-4),Tris-EDTA抗原修复液(pH 9.0) (货号G1203), 水浴100℃, 25分钟. —抗: 1: 500稀释, 4℃ 孵育过夜. 二抗: S-vision免疫组化多聚二抗(山羊抗小鼠), 即用型(货号G1301), 室温孵育20分钟. |
| IHC检测STAT3蛋白(货号 GB15176). 样品: 人食管癌, 4%多聚甲醛 (货号G1101) 固定12-24小时. 抗原修复: 抗原修复仪(货号 ARI-4),Tris-EDTA抗原修复液(pH 9.0) (货号G1203), 水浴100℃, 25分钟. —抗: 1: 500稀释, 4℃ 孵育过夜. 二抗: S-vision免疫组化多聚二抗(山羊抗小鼠), 即用型(货号G1301), 室温孵育20分钟. |
| IF检测STAT3蛋白(货号 GB15176)(红色). 样品: 人宫颈癌, 4%多聚甲醛 (货号G1101) 固定12-24小时. 抗原修复: 抗原修复仪(货号 ARI-4),Tris-EDTA抗原修复液(pH 9.0) (货号G1203), 水浴100℃, 25分钟. 封闭: 3% BSA(货号GC305010)的PBS溶液, 室温孵育30分钟. —抗: 1: 500稀释, 4℃ 孵育过夜. 二抗: Cy3标记山羊抗小鼠IgG (H+L) (货号GB21301), 1: 300稀释, 室温孵育1小时. |
| IF检测STAT3蛋白(货号 GB15176)(红色). 样品: 人胶质母细胞瘤, 4%多聚甲醛 (货号G1101) 固定12-24小时. 抗原修复: 抗原修复仪(货号 ARI-4),Tris-EDTA抗原修复液(pH 9.0) (货号G1203), 水浴100℃, 25分钟. 封闭: 3% BSA(货号GC305010)的PBS溶液, 室温孵育30分钟. —抗: 1: 500稀释, 4℃ 孵育过夜. 二抗: Cy3标记山羊抗小鼠IgG (H+L) (货号GB21301), 1: 300稀释, 室温孵育1小时. |
| IF检测STAT3蛋白(货号 GB15176)(红色). 样品: 人乳腺癌, 4%多聚甲醛 (货号G1101) 固定12-24小时. 抗原修复: 抗原修复仪(货号 ARI-4),Tris-EDTA抗原修复液(pH 9.0) (货号G1203), 水浴100℃, 25分钟. 封闭: 3% BSA(货号GC305010)的PBS溶液, 室温孵育30分钟. —抗: 1: 500稀释, 4℃ 孵育过夜. 二抗: Cy3标记山羊抗小鼠IgG (H+L) (货号GB21301), 1: 300稀释, 室温孵育1小时. |
储存
| 储存条件 | 在-20℃下储存一年, 避免反复冻融. |
| 储存缓冲液 | 含0.15% ProClin300防腐剂, 100 μg/mL牛血清白蛋白和50%甘油的磷酸盐缓冲液. |
注意:
1.本产品仅供研究使用.
2.建议用一抗稀释液(G2025)稀释本产品.
| 货号 | 名称 | 规格 | 价格 | 操作 |
|---|
| 货号 | 名称 | 规格 | 价格 | 操作 |
|---|